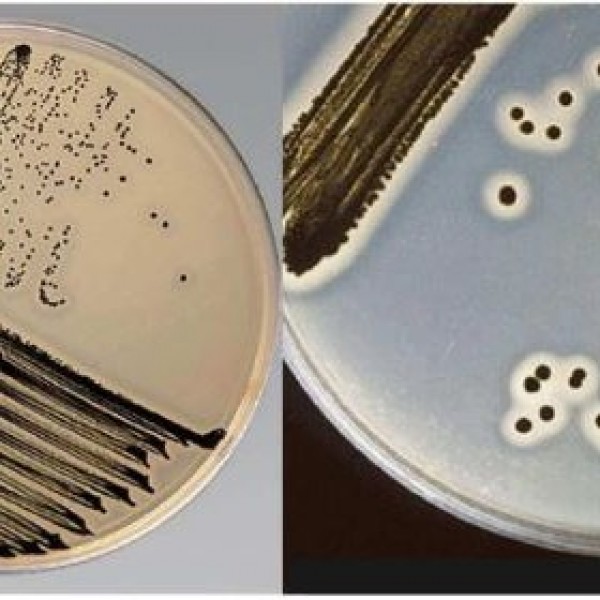

Baird Parker Agar - Staphylococcus Aureus
BAIRD PARKER ASAR- STAPHYLOCOCCUS AUREUS
Uygun clilusyondan yayma yöntemi ile ekim yapıldıktan sonra 37 C'da 48 saat inkubasyon sonucunda üreyen siyah, etrafında tipik şeffaf zon oluşmuş koloniler S. aureus olarak sayılır.
Koagülaz stafılokoklar (Staphylococcus aureus) sınırları belirli, şeffaf
zonlara sahip koyu gri ila siyah renkte, çevresinde opak zonlu veya opak zon olmaksızın parlak konveks koloniler üretir.
Koagülaz negatif stafilokok gri ila siyah kolonilerde genellikle şeffaf veya opak zonlar görülmeden, zayıf gelişme gösterir veya hiç gelişme göstermez. Stafilokoklar dışındaki organizmalar genelde inhibe edilir.
Eğer gelişim gözlenirse, koloniler şeffaf veya opak zonlar görülmeden kahverengi ila gri veya renksiz olabilir.